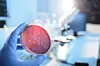

Rundt 70 dør årlig av resistente bakterier i Norge
I Europa dør 33.000 mennesker årlig som følge av antibiotikaresistens, viser en bredt anlagt studie. I Norge dør rundt 70 personer av samme årsak.
Denne artikkelen er mer enn 2 år gammel og kan inneholde utdatert informasjon.
Det oppstår årlig 672.000 infeksjoner som er resistente mot antibiotikabehandling i Europa, rapporterer Det Europeiske smitteverninstituttet (ECDC) via Folkehelseinstituttet.
I samme undersøkelse går det fram at 1.900 personer i Norge årlig får en infeksjon av bakterier som er motstandsdyktige mot antibiotika. Av disse dør om lag 70 personer.
Studien bygger på overvåkingsdata fra 2015 fra 30 land i EU og EØS-området. Forskerne har sett på 16 ulike kombinasjoner av bakterier og antibiotikaresistens.
Forsker Petter Elstrøm ved Folkehelseinstituttet har deltatt i studien. Han sier beregningene stemmer godt overens med overvåkingsdataene som er samlet inn her i landet.
– Med tanke på at årsaken til infeksjoner ikke alltid blir identifisert, vil jeg si at resultatene i studien samsvarer med de overvåkingsdataene vi har i Norge, både for MRSA-infeksjoner og for andre infeksjoner av resistente bakterier som blir meldt inn, sier Elstrøm i en pressemelding fra Folkehelseinstituttet.
Den årlige kostnaden for antibiotikaresistens i Norge er beregnet til omtrent 2 milliarder kroner. Her er faktorer som nedsatt funksjonsevne og for tidlig død forsøkt omregnet i kroner.
Forekomsten av resistente bakterier har økt betydelig de siste åtte årene.
Overlege og professor Dag Berild ved Oslo universitetssykehus ser alvorlig på situasjonen.
– Jeg er svært bekymret for resistenssituasjonen i Norge og Europa. Vi kan bremse dette ved å redusere bruken av antibiotika, men det tar lang tid før man ser effekten av et fall i forbruket av antibiotika, sier Berild til NTB.
Norge og en rekke andre land har iverksatt tiltak for å redusere antibiotikabruken. I september kom Folkehelseinstituttet med en rapport som viser at forbruket av antibiotika i Norge er redusert med 21 prosent siden 2012. Veterinærinstituttet la samtidig fram en rapport som viser at landbruket allerede har nådd sitt mål om å redusere bruken av antibiotika til matproduserende dyr med 10 prosent innen 2020.
Norge og de øvrige landene i Norden blant dem som kommer best ut i undersøkelsen fra ECDC. Land langt sør i Europa er sterkere rammet av ringvirkningene som følge av resistens.
Landet som er hardest rammet, er Italia, hvor 202.000 mennesker årlig får infeksjon av antibiotikaresistente bakterier. Nesten 11.000 mennesker dør årlig i Italia som følge av bakteriene.
Dag Berild mener nordmenns reiser til land som har høy utbredelse av antibiotikaresistente bakterier kan bidra til at vi også får flere tilfeller her hjemme.
– Vi vil importere flere resistente bakterier fra utlandet fordi vi reiser mye i Sør-Europa og Asia hvor forekomsten er mye høyere enn i Norge og stadig øker. Vi bidrar også selv til økning i resistens fordi vi bruker mer resistensdrivende, bredspektrede antibiotika enn det som er nødvendig, sier Berild.
Han viser til at det for øyeblikket ikke er noen nye antibiotika på vei, og at det nå er 30 år siden det siste antibiotikumet kom på markedet.
– Vi er under dobbel ild: Vi har økende resistens og ingen nye antibiotika, sier Berild.
(©NTB)














